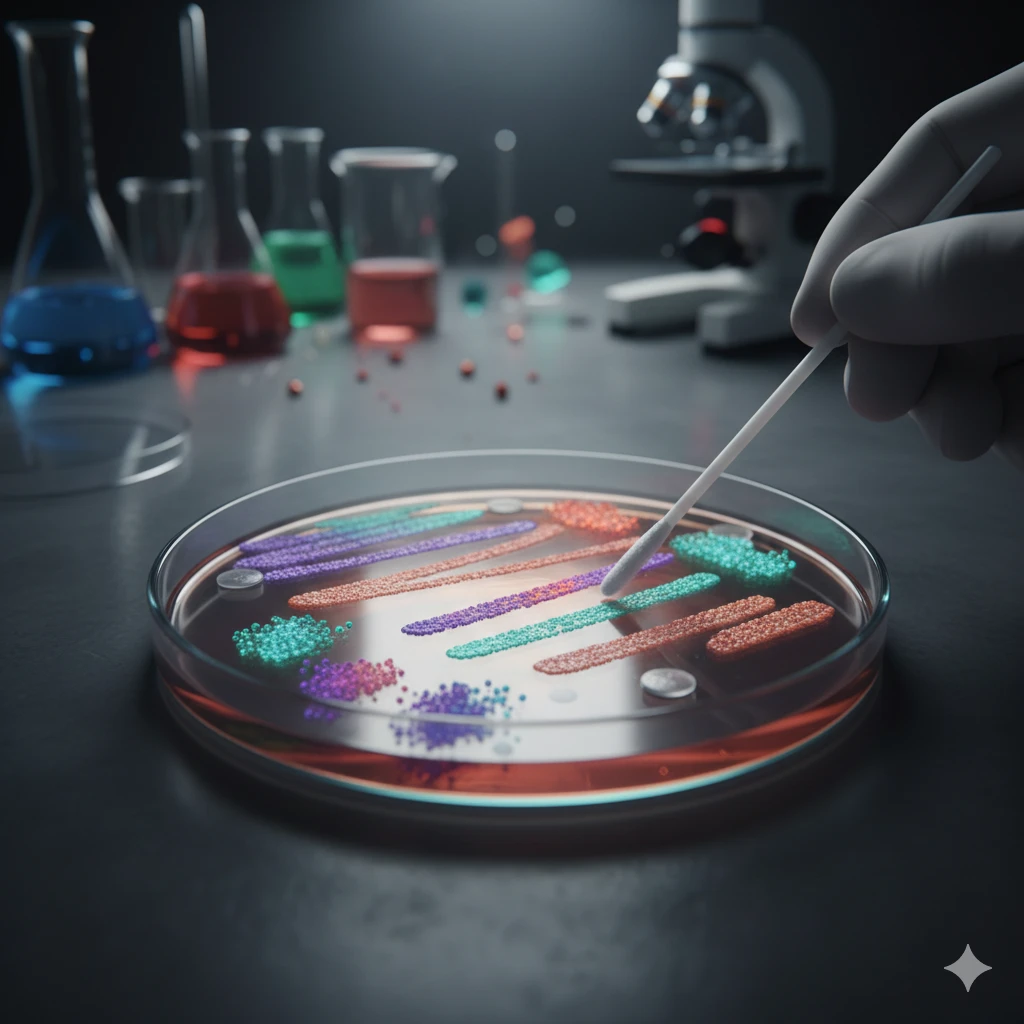
Throat Swab Culture and Sensitivity

تفاصيل التحليل
Throat Swab Culture and Sensitivity
لا تدع آلام الحلق ترهقك. يحدد هذا التحليل بدقة إذا كان التهاب حلقك ناتجاً عن بكتيريا بحاجة لمضاد حيوي، أم فيروس لا يحتاجه. كما يبين أنسب مضاد للعلاج، مما يحميك من استخدام دواء غير فعال ويسرع شفاءك.
الصورة التوضيحية المرتبطة بهذا التحليل